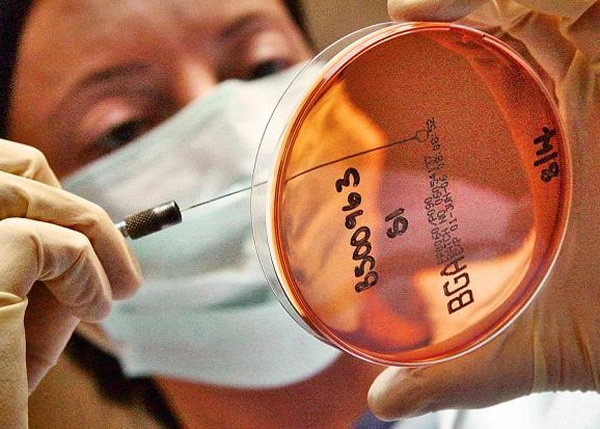
专家指新药“Staphefekt”具比旧有抗生素更佳效能。

荷兰生物科技公司Micreos成功研发能代替传统抗生素的新疗法Staphefekt
专家指新药“Staphefekt”具比旧有抗生素更佳效能。
专家指新药可有效消灭抗药性金黄葡萄球菌(图)等病菌。
(蜘蛛网报道)荷兰生物科技公司Micreos,近日成功研发能代替传统抗生素的新疗法Staphefekt,此被视为是医学界的重大突破。新疗法现时已在皮肤敏感软膏中使用,相信5年内可研发药丸或注射用药物。
报道指,该公司研制名为“Staphefekt”的细胞内溶素(Endolysins),以此取代旧有的抗生素。此药物具有极佳杀菌功能,又不会伤害其他微生物,它们可以在抗药性金黄葡萄球菌等具抗药性的细菌中,于细菌外层进行撕破,从而进入细胞进行杀菌工作。
专家在病人测试中发现,每6名病人当中,有5人对该药物有效,有关研究结果周三在英国伦敦的记者会中发布,据称此药相信能让数百万人得益。